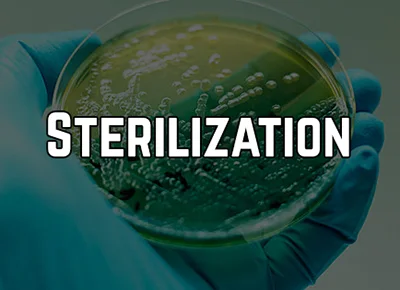

🎤 John E. Lincoln | 📅 Recording Available | 🕒 90 Minutes
| Description: This webinar will outline the required elements of a successful ethylene oxide (EO) sterilization validation process for medical devices as required by ISO 11135:2014. Hardware / chamber and software considerations and required documentation. Temperature and humidity mapping, BIs / PCDs and their placement. Basic system. A brief discussion of the lethal rate BI / bioburden approach, and a more detailed discussion of the more commonly used Overkill approach descriptions, IQ, OQ, PQ – MPQ / PPQ.
|
Why You Should Attend:
Basic information of the EO sterilization process for successful medical device sterilization to meet ISO 11135 / U.S. FDA and EU MDR requirements. Discussion of the purpose and methodology for the various partial and full cycles, IQ, OQ, PQs, acceptance criteria, and a suggested report format. Useful whether a company will do the validation, contract for it, hire a consultant to assist, or review existing sterilization documentation of a vendor.
Areas Covered in the Session:
- Key parts of ISO 11135:2014, and its implementation
- Control software description and suggested documentation (11 elements)
- Temperature and humidity mapping
- BI and PCD number and placement considerations
- Contract Lab Resources, B&F, BIs, residuals, sterility testing
- Fractional, Half-Cycle and Full Cycle runs
- IQ, OQ, PQs (MPQs and PPQs) test cases
- Pre- and Post (Aeration)- Conditioning
- Putting it all together – the Sterilization V&V Test Report.
- Revalidation frequency, considerations, and alternatives
Who Should Attend:
- Quality Assurance Departments
- QAE Personnel
- Regulatory Affairs Departments
- Research and Development Departments
- Engineering Departments
- Manufacturing Departments
- Operations Departments
- Production Departments
- Software Engineers
- Sterilization Personnel
- Marketing Departments
- Purchasing Departments
- Consultants
- Everyone tasked with product development, and sterilization / product sterility